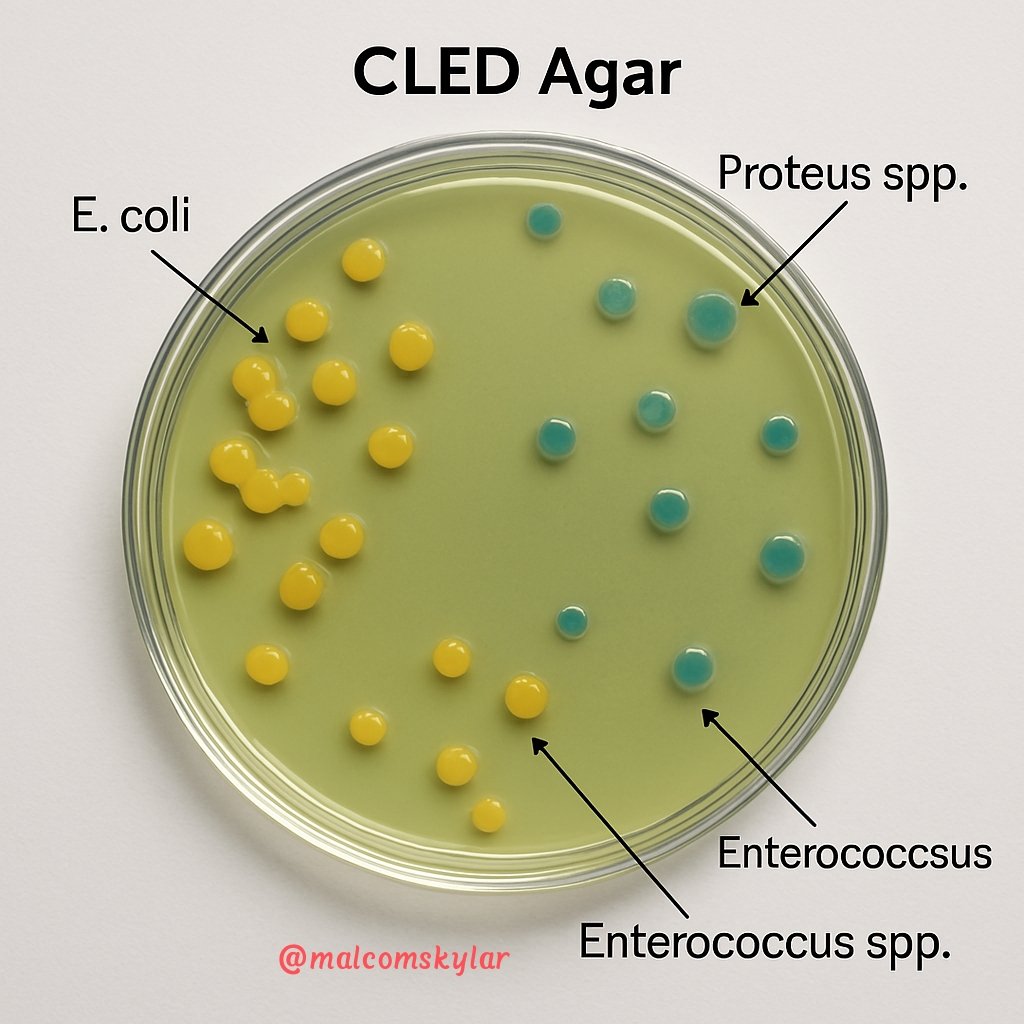
Malcomskylar's tweet image. 🧫 #CLED #Agar
Non-selective, differential medium used for:
  - Isolation and enumeration of #urinary #pathogens
  - Differentiation of #lactose fermenters vs non-fermenters
- Designed to prevent #swarming of #Proteus spp. by omitting electrolytes
#malcomskylar #microbiology

#cled search results
Lola wore the #Cled •Duo Beam Ring - Blue & Brown/Mint & Blue Jay ($270 each) •Duo Sculpture Ring - Algae & Dew/Coal & Snow ($190 each) •Beam Ring - Blue Ocean ($185) •Beam Ring | Marble - Sea/Lavender ($185 each) During a The Summer I Turned Pretty Press Day.



#Spotlighton Arev Hambardzumyan, lead engineer & CTO @RAFA_Solutions, experienced #CLED #CLA, #LabVIEWChampion and #systems #architecture specialist. Hear her speak at #GDevCon on perfecting the User Experience in your #LabVIEW GUI! #Booknow universe.com/gdevcon2

Zoom sur la marque de bijoux californienne qui pousse l'upcycling à son plus haut niveau #Cled #Bijoux #Coupdecoeur >> madame.lefigaro.fr/bijoux-et-mont…


The new Crystal LED series providing overwhelming immersive images that stimulate the creativity of creators youtu.be/abjZq-3qRj8 #CrystalLED #CLED #LED #display #creative #entertainment #adtech #DigitalSignage #wallmounted #techology
Forte affluence ce soir au campus de @villedelorgues pour la réunion commune du #cled et de #dracetech

ㅤ #Seungyeon painted sweat and sweat 2021 #Cled Bell New Year Cushion Who wants to have it! when you participate in the event Seungyeon New Year's cushion with a New Year's feel cute Seungyeon gets a certified photo! let's go to Instagram and participate! ㅤ ㅤ


Checking out @Sony's #8K Theater activation. Showcasing a 440" Crystal LED #CLED screen. This amazing activation is completely #FREE. Stop by Grimes Studio in Austin. #Sony #SXSW #SXSW2019 #SonyatSXSW
Watch to find out how Sony’s Virtual Production/In-Camera VFX is transforming productions and film and TV sets by allowing captured locations to be displayed as a background image on a Crystal LED display. bit.ly/3gTMtJp #CLED #dvLED #avtweeps #AVnews #virtualproduction

Group time at CLED training this morning. Do you give and incentive or not? What do you offer? How do you justify? @LIDEALA @LSBDCSLU #economicdevelopment #CLED

We're excited to be partnering with Sony to bring the Crystal LED to you! Their 110" 1.2mm CLED will be in SLC on May 11th (11am-4pm) at the Courtyard Marriott (345 West 100 South). Contact us if you'd like more details!! #CLED #CrystalLED #Sony @SonyProUSA




The anti-reflective coating of the Crystal LED B-Series displays eliminates reflection to free video production lighting options and reduce post-production editing, time, and cost. bit.ly/3vt1ea1 #CLED #dvLED #avtweeps

À vos marques, prêts, lisez! Visitez votre bibliothèque et inscrivez-vous au Club de lecture d’été TD! @TDSRC_CLED #CLED ow.ly/4EtX30kwacV

Artwork by CLED📝 做专辑的路上变身BUSYMAN繁忙侠🤓 #StarboyWang #CLED #busyman #GVO对音乐 #cyberpunk #cartoon #artwork #cloudwang #lany2bjcd instagram.com/p/CH0C9zpHZmU/…
#VIDEO #SantiagoPerry nos cuenta cómo será la vinculación de la Corporación PBA al proyecto #CLED que financia @Nuffic y ejecuta Maastricht School of Management con @UtrechtUni , @La_Fup y @crepic . El proyecto aborda el Desarrollo Económico Local del Cauca @CamilOviedo1
🧫 #CLED #Agar Non-selective, differential medium used for: - Isolation and enumeration of #urinary #pathogens - Differentiation of #lactose fermenters vs non-fermenters - Designed to prevent #swarming of #Proteus spp. by omitting electrolytes #malcomskylar #microbiology




久しぶりのサブスク配信⚙️ linkco.re/91EM2t8d #Cled #鹿児島 #hiphop #rap
Cled - 地元のFriends(Remix) feat.23fuz & Buu goat (Music video) youtu.be/Om-kGcdnW3I?si… @YouTubeより #Cled #鹿児島 #mv #hiphop #rap #日本語ラップ

youtube.com
YouTube
Cled - 地元のFriends(Remix) feat.23fuz & Buu goat (Official Music Video)
こっちも聴いて✈️ 地元のFriends(2024/3/20) linkco.re/p4MhQh9B #Cled #鹿児島 #hiphop #rap
Xの存在忘れてた、 天邪鬼(2023/12/28 Release) linkco.re/ERCACHrG #Cled #鹿児島 #hiphop #rap
Une partie du bureau se regroupe pour la 2ème soirée des Trophées de l'Économie en Dracénie. 🙌🏼👌🏻 Plusieurs nominations en jeu ! #cled #puresport #trophee #lecled

#Sony unwraps new #CLED displays aimed at virtual production. #Sonydisplay #display #LED #LEDdisplay #Technews #TechnologyNews #techtwitter #TechTrends #techno #techtalk #TECH4ALL #technologies #Innovation #techindustry #development #LatestNews #UPDATE

🙏au #CLED & @MarquiePhilippe pour leur invitation hier soir aux #arcssurargens afin de rencontrer les adhérents. ✅ Information sur la prestation de conseil en Ressources Humaines (PCRH) ✅ Echanges avec les entrepreneurs 👏pour l'organisation #tousmobilisés




torque testing for scaffold ratchet wrench before delivery #scaffoldingtools #ratchetwrench #ChaveCatracaAndaime #socket #spanner #ratchetscaffoldwrench #scaffoldwrench #Doppelratschenschlüssel #Cléd'#ratschenschlüssel #Gerüstbauratsche #Gerüstbauknarre #trinquetedeandamiode
Lola wore the #Cled •Duo Beam Ring - Blue & Brown/Mint & Blue Jay ($270 each) •Duo Sculpture Ring - Algae & Dew/Coal & Snow ($190 each) •Beam Ring - Blue Ocean ($185) •Beam Ring | Marble - Sea/Lavender ($185 each) During a The Summer I Turned Pretty Press Day.



Lola wore the #Cled •Duo Beam Ring - Blue & Brown/Mint & Blue Jay ($270 each) •Duo Sculpture Ring - Algae & Dew/Coal & Snow ($190 each) •Beam Ring - Blue Ocean ($185) •Beam Ring | Marble - Sea/Lavender ($185 each) During a The Summer I Turned Pretty Press Day.




#Spotlighton Arev Hambardzumyan, lead engineer & CTO @RAFA_Solutions, experienced #CLED #CLA, #LabVIEWChampion and #systems #architecture specialist. Hear her speak at #GDevCon on perfecting the User Experience in your #LabVIEW GUI! #Booknow universe.com/gdevcon2

Desde el #CLED se hizo el Cierre del Debate de la #LeyChambaJuvenil en el estado #DeltaAmacuro contando con la participación de fuerzas juveniles, Acompañados de los Diputados de la @Asamblea_Ven Legisladores regionales y Concejales. @NicolasMaduro @dcabellor @GobLizeta @rodbexa




🧫 #CLED #Agar Non-selective, differential medium used for: - Isolation and enumeration of #urinary #pathogens - Differentiation of #lactose fermenters vs non-fermenters - Designed to prevent #swarming of #Proteus spp. by omitting electrolytes #malcomskylar #microbiology

Zoom sur la marque de bijoux californienne qui pousse l'upcycling à son plus haut niveau #Cled #Bijoux #Coupdecoeur >> madame.lefigaro.fr/bijoux-et-mont…

Forte affluence ce soir au campus de @villedelorgues pour la réunion commune du #cled et de #dracetech

#CLED #Legendary NFTがサイクル3 になって、マイニングできる量が減ってる! 良かったー サイクル2のレジェンダリーNFTを買って しかも 5500CLEGだったから 超良い投資だったかも♪ 初期組になればなるほど、この世界は美味しいね


ㅤ #Seungyeon painted sweat and sweat 2021 #Cled Bell New Year Cushion Who wants to have it! when you participate in the event Seungyeon New Year's cushion with a New Year's feel cute Seungyeon gets a certified photo! let's go to Instagram and participate! ㅤ ㅤ



The anti-reflective coating of the Crystal LED B-Series displays eliminates reflection to free video production lighting options and reduce post-production editing, time, and cost. bit.ly/3vt1ea1 #CLED #dvLED #avtweeps

Watch to find out how Sony’s Virtual Production/In-Camera VFX is transforming productions and film and TV sets by allowing captured locations to be displayed as a background image on a Crystal LED display. bit.ly/3gTMtJp #CLED #dvLED #avtweeps #AVnews #virtualproduction

#Sony unwraps new #CLED displays aimed at virtual production. #Sonydisplay #display #LED #LEDdisplay #Technews #TechnologyNews #techtwitter #TechTrends #techno #techtalk #TECH4ALL #technologies #Innovation #techindustry #development #LatestNews #UPDATE

Group time at CLED training this morning. Do you give and incentive or not? What do you offer? How do you justify? @LIDEALA @LSBDCSLU #economicdevelopment #CLED

Something went wrong.
Something went wrong.
United States Trends
- 1. #DWTS 36.6K posts
- 2. Alix 10.3K posts
- 3. Robert 98.5K posts
- 4. Elaine 34.5K posts
- 5. Carrie Ann 3,429 posts
- 6. Anthony Black 2,223 posts
- 7. Dylan 31.4K posts
- 8. Drummond 2,314 posts
- 9. #WWENXT 6,764 posts
- 10. Suggs 2,241 posts
- 11. Jalen Johnson 3,725 posts
- 12. Ezra 10.8K posts
- 13. Daniella 2,578 posts
- 14. #DancingWithTheStars 1,102 posts
- 15. Godzilla 31.4K posts
- 16. Wizards 8,741 posts
- 17. CJ McCollum 1,511 posts
- 18. Bruce Pearl N/A
- 19. #NXTGoldRush 5,433 posts
- 20. Brown 154K posts





























































































